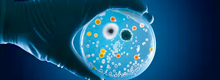

Artikuluak
-
Heste-mikrobiota, sindrome metabolikoarekin lotutako asaldurak kudeatzeko diana terapeutiko gisa
2025eko ekainak
-
Opuntia stricta var. dilleniiestraktuek obesitatearen kontra dituzten efektuak 3T3-L1 aurre adipozito eta adipozito helduetan
2025eko maiatzak
-
Nori y wakame: consumir algas marinas podría favorecer la microbiota intestinal y prevenir enfermedades
2025eko maiatzak
-
Guía rápida para entender el etiquetado de los alimentos (y la letra pequeña)
2021eko otsailak
-
¿Es imprescindible comer la fruta con piel para ingerir suficiente cantidad de fibra?
2021eko otsailak
-
Los efectos secundarios de las pastillas del colesterol podrían estar solo en nuestra mente
2021eko urtarrilak